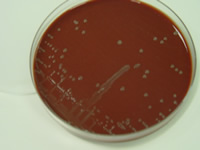

L'isolement d'H. parasuis quand il y a un épisode clinique est un travail difficile et un vrai défi pour beaucoup de vétérinaires. Les chances de succès peuvent être accrues en suivant quelques règles. Les facteurs influençant l'isolement vont du choix des animaux et des tissus prélevés jusqu'au milieu de transport et à l'envoi des échantillons. Dans cet article, on décrit quelques mesures qui nous aideraient à améliorer les possibilités de détection d'H. parasuis au cours d'un épisode clinique suspect.
Choix des animaux
Les prélèvements doivent être faits sur des animaux non traités et touchés de façon aiguë puisque H. parasuis est rarement retrouvé dans des lésions chroniques; les meilleurs "candidats" sont des porcelets avec des problèmes respiratoires et des articulations enflammées. Par ailleurs, les chances de succès augmentent en prélevant des animaux sacrifiés plutôt que des animaux déjà morts depuis un moment. Le choix de 10 à 20 animaux peut permettre, selon la taille de l'élevage, l'identification des souches les plus prévalentes d'H. parasuis dans l'élevage.
Prise d'échantillons
Haemophilus parasuis
est un organisme commensal de l'appareil respiratoire supérieur et on peut
l'isoler dans la cavité nasale, les amygdales et la trachée d'animaux
sains; par conséquent, en cas d'épisode clinique, il est préférable
d'éviter ces sites et de prélever dans les
méninges, le péricarde, la plèvre, le péritoine et/ou
les articulations ayant de la fibrine en surface. On peut aussi faire
des prélèvements sur des animaux vivants , par exemple de liquide
synovial sur une articulation enflammée en utilisant une seringue
Haemophilus parasuis
est un organisme commensal de l'appareil respiratoire supérieur et on peut
l'isoler dans la cavité nasale, les amygdales et la trachée d'animaux
sains; par conséquent, en cas d'épisode clinique, il est préférable
d'éviter ces sites et de prélever dans les
méninges, le péricarde, la plèvre, le péritoine et/ou
les articulations ayant de la fibrine en surface. On peut aussi faire
des prélèvements sur des animaux vivants , par exemple de liquide
synovial sur une articulation enflammée en utilisant une seringueOn peut aussi utiliser des écouvillons stériles immergés dans un milieu de transport Amies. Si on observe une pleurésie fibrineuse, on peut envoyer au laboratoire du tissu pulmonaire, ce qui améliore la viabilité d'H. parasuis pendant le transport. Bien que cette bactérie provoque une septicémie, il est pratiquement impossible de la détecter dans le sang.
Ce micro-organisme est très sensible aux températures élevées: il survit seulement 1 heure à 42ºC, 2 heures à 37ºC et 8 heures à 25ºC. En revanche, si les échantillons sont tenus au froid (4ºC) H. parasuis peut survivre entre 1 et 2 jours.
Simone Oliveira. Improving rate of success in isolating Haemophilus parasuis from clinical samples. J Swine Health Prod 2004;12(6)




